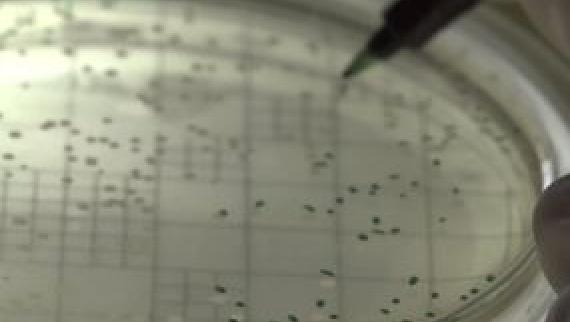
Man marcando "Unidades de Formación de Colonias" nunha placa Petri.

Organization
A clear, well-planned organization is key to understand the function and strategy of an institution.
The different departments and positions that compose the IIM-CSIC reflect the diversity of the center, as well as a planned effort to reach its goals while minimizing resource use.
The IIM is a Research Institute belonging to the Spanish Research Council State Agency ("Centro Propio del CSIC"), a Public Research Organization under the Spanish General State Administration. As such, the Institute is not an independent legal entity but nevertheless works with full scientific autonomy, being managed through a decentralized and responsible system.
The organization of the Institute of Marine Research is currently modifying its structure to fully comply with the Regulations approved by the CSIC's Governing Board Ruling from November 2021.
The highest governing body of the center is the Directorate (Equipo Directivo), the executive arm of the Institute, together with the Governing Board (Xunta or Junta), which includes the Directorate itself, the Staff Representatives, the Heads of the four Research Departments and the Institute Manager. The latter is the person in charge of coordinating the administrative procedures of the Institute, as well as its economic sustainability and estate.
The scientific activity at the IIM-CSIC is corporately organized through 14 research groups divided into four research departments. The Scientific Board (Claustro Científico) is in charge of deliberation on the center’s scientific matters and includes all PhD staff members of the Institute. Finally, the Strategic Units (IACIC, UCC, UPSE and UACT) manage resources, provide strategic advice and develop transversal projects that are necessary for IIM to reach its goals.
The most visual way of discovering how the Institute of Marine Research is organized is to have a look at our Organizational Chart. Last updated on January 2022. Awaiting an update from the new Directorate as of September 2024.

The highest governing body of the center is the Directorate, composed of the Director and Vice-Directors. They are in charge of devising the strategy of the center and ensuring that its goals are reached. It directly coordinates the action of our Internationalisation & Transfer Unit (IACIC) and our Engagement with Society Unit (UCC+i).

Our work on research and innovation and our commitment with society could not be properly fulfilled without the help of professionals who ensure that our documentation, our information technologies, our aquariums and the general maintenance of our appliances and facilities are properly taken care of. These are our General Services.